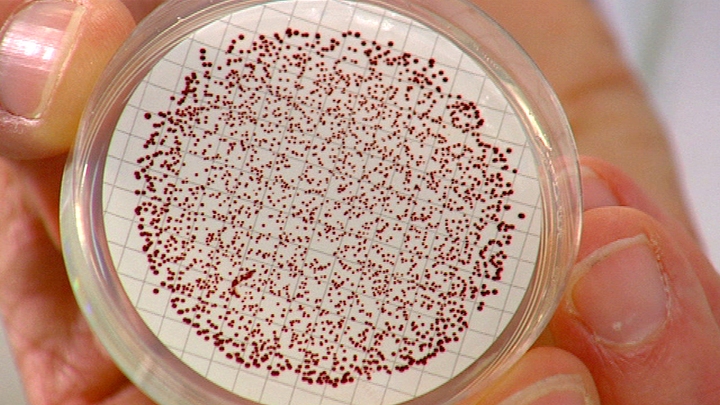
Swimming In It

Swimming In It
Dangerous microbes absorbed in rain are flowing into the sea creating health risks for swimmers.
Dangerous microbes absorbed in rain are flowing into the sea creating health risks for swimmers.
Scientific research across Australia is showing how pathogens and viruses in water are being rained down and flowing into the oceans. These microbes often take days to dissipate, and during this time, when the swimmers return with the sun, they are risking diseases such as Salmonella and Hepatitis A.
FULL SYNOPSIS

